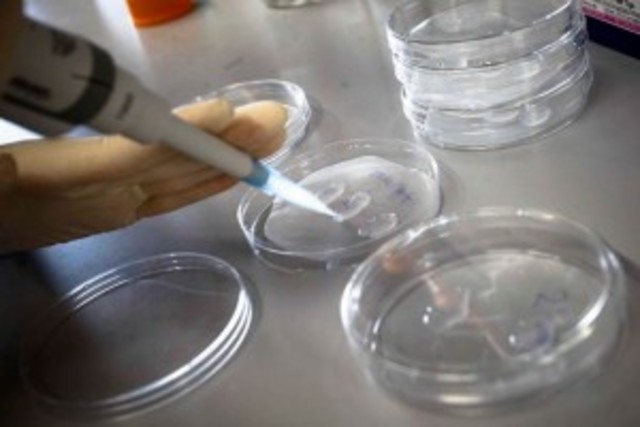
Descubren reacción bioquímica clave en reprogramación celular

-
-
Louis Pasteur mostró que los microorganismos no se formaban espontáneamente en el interior de un caldo, refutó la teoría de la generación espontánea y demostró que todo ser vivo procede de otro ser vivo anterior (Omne vivum ex vivo)
-
Johann Gregor Mendel postuló la existencia de entes de naturaleza desconocida e inmutable (los genes) responsables de la transmisión de los caracteres hereditarios. Experimentos sobre la forma en la que se transmiten los caracteres heredables. Dieron lugar a las leyes fundamentales de la herencia.
-
Aisló núcleos a partir del pus de los vendajes usados en el hospital. Tras un tratamiento simple, comprobó que estaban formados por una única sustancia química muy homogénea y no proteica, que denominó nucleína (sustancias ricas en fósforo localizadas exclusivamente en el núcleo celular)
-
Publica El Origen del Hombre; señala la evolución de éste desde formas inferiores
-
Wilhelm Friedrich Kühne propone que se llame enzima a los catalizadores orgánicos que existen fuera de la célula.
-
Hermann Fol observa por primera vez la fecundación de un óvulo por un solo espermatozoide. Pionero de los estudios microscópicos de fecundación y división celular.
-
Robert Koch descubre la bacteria causante de la tuberculosis y establece postulados que afirman las condiciones para que un organismo sea considerado la causa de una enfermedad.
-
Walther Flemming y Robert Feulgen desarrollaron nuevas técnicas de tinción y lograron visualizar los cromosomas en división, lo que les permitió describir la manera en que se replican los cromosomas (la mitosis). Para explicar esto, se publica La Sustancia Celular, El Núcleo y la División Celular.
-
Francis Galton hace énfasis en el término eugenesia: eliminación de individuos que la ciencia convencional considera ser portadores de genes defectuosos o que no cumplen con los estándares genéticos y biológicos fijados.
-
Santiago Ramón y Cajal demostró la doctrina de la neurona, basada en que el tejido cerebral está compuesto por células individuales. También, enfatizó en la ley de polarización dinámica. Ésta dice que la transmisión del movimiento nervioso es direccional y se debe a las relaciones entre las neuronas y el comienzo de la excitación.
-
Martinus Willem Beijerinck demostró que el agente patógeno responsable de la enfermedad del mosaico del tabaco es mucho más pequeño que una bacteria. Él los nombra virus.
-
Richard Altmann utiliza técnicas físico-químicas para describir la nucleína y por primera vez la denomina ácidos nucleicos.
-
El aporte de Camilo Golgi se relaciona con el estudio del tejido nervioso. Su método de tinción con nitrato de plata causó una revolución en el estudio de laboratorio del tejido nervioso. Empleando este método, se identificó una clase de célula nerviosa con dendritas, mediante el cual se produce la interconexión con otras células nerviosas.
-
Thomas Morgan comenzó a trabajar en el desarrollo embrionario de Drosophila melanogaster. Reconoció la presencia de los cromosomas sexuales y de lo que se conoce en genética como “herencia ligada al sexo”. Demostró que los genes se disponían de forma lineal sobre los cromosomas.
-
Alfred Henry Sturtevant demuestra que algunos de los genes tienden a heredarse juntos, por lo que se deduce que se colocan de forma lineal sobre el cromosoma. Elabora el primer mapa genético de un organismo: Drosophila melanogaster
-
Phoebus Levene identifica componentes básicos de los ácidos nucleicos; los azucares y las bases nitrogenadas. Da luces sobre la existencia del esqueleto base nitrogenada - azucar.
-
Se creía que las plantas sólo poseían ARN y los animales ADN
-
Hermann Joseph Muller descubrió la acción mutágena de los rayos X, lo cual permitió adquirir conocimientos fundamentales sobre la estructura y movilidad de los genes.
-
Alexander Fleming descubrió el antibiótico penicilina; sustancia sintetizada por el hongo Penicillium. Utilizada en el tratamiento de infecciones provocadas por bacterias sensibles.
-
Descubrió cómo el Streptococcus pneumoniae inocuo puede transformarse en virulento al infectar un ratón sano con la cepa avirulenta viva y la virulenta muerta.
-
Torbjorn Caspersson y Einar Hammarsten encontraron que el ADN era un polímero; éste es generado a partir de cuatro tipos de nucleósidos: adenosina, guanosina, citidina y timidina, cada uno está compuesto de un azúcar (desoxirribosa) y una base nucleica (adenina, guanina, citosina y timina).
-
A.N Belozersky extrae ADN puro de las plantas. Así demuestra que éstas tienen los dos tipos de ácidos nucleicos.
-
Técnica que emplean los cientificos en el laboratorio, utilizada para separar el ADN, el ARN, moléculas o proteínas en base a su tamaño y carga eléctrica. Se utiliza una corriente eléctrica para mover las moléculas y que se separen a través de un gel. Las condiciones utilizadas durante la electroforesis se pueden ajustar para separar moléculas en el rango de tamaño que se desee. -Arne Wilhelm Kaurin Tiselius
-
Oswald Avery, Maclyn McCarty, Colin MacLeod, demostraron que las cepas avirulentas de Griffith se transformaban en virulentas con la exposición al ADN, pero no a las proteínas.
Así mismo, se demostró claramente que el ADN era el factor de transformación (FT) -
George Wells Beadle y Edward Lawrie Tatum realizaron un experimento, el cual implicaba exponer el moho Neurospora crassa a rayos X, causando mutaciones. Así, demostraron que esas mutaciones causaban cambios en las enzimas específicas implicadas en las rutas metabólicas. Esto llevó a proponer un vínculo directo entre los genes y las reacciones enzimáticas conocida como la hipótesis "Un gen, una enzima".
-
Erwin Chargaff descubre las leyes de complementariedad de bases de los ácidos nucleicos. Establece que la cantidad de adenina es igual a la cantidad de timina y la cantidad de guanina es igual a la cantidad de citosina. La proporción era igual en todas las células de los individuos de una especie dada, pero variaba de una especie a otra.
-
Rosalind Franklin trabajó y fotografió el ADN. Utilizó la difracción de rayos X para capturar la estructura de doble hélice del ADN, algo detectable a simple vista por las bandas dispuestas en cruz. Fotografía 51
-
Martha Hershey y Alfred Chase con sus experimentos empleando el fago T2, apoyan la tesis de Avery sobre la molécula de ADN como portadora del material genético.
-
Proponen las estructuras de hélice α y hoja plegada β en las
proteínas. -
James Watson y Francis Crick propusieron el modelo de doble hélice que detalla la estructura tridimensional del ADN.
-
Determina por primera vez la secuencia aminoacídica de una proteína (insulina).
-
-
Aisló la enzima de una célula de Escherichia Coli, que él denominó polinucleótido fosforilasa y que luego fue conocida como ARN polimerasa. Así mismo, consiguió sintetizar ARN in vitro, descubrimiento esencial para descifrar posteriormente el código genético.
-
Las investigaciones más notables de Heinz Fraenkel-Conrat fueron sobre el virus del mosaico del tabaco. Descubrió que el control genético de la reproducción viral estaba determinado por el ARN.
-
Se identifican 23 pares de cromosomas en las células del cuerpo humano.
-
Matthew Meselson y Franklin Stahl demostraron que el ADN se replica de manera semiconservativa. El experimento Meselson-Stahl muestra que cuando el ADN se replica, las dos cadenas que lo forman se separan, sirviendo cada una de ellas como plantilla para la síntesis de la cadena replicada.
-
Paul Zamecnick y Mahlon Hoagland descubren que la molécula de ARNt funciona como un adaptador. Estos llevan los aminoácidos al ribosoma y emparejan un codón en el ARNm con el aminoácido para el que codifica.
-
Francis Crick propone la hipótesis del adaptador. Así, sugirió que pequeñas moléculas de ácido ribonucleico junto con diversas enzimas, funcionan como intermediarios entre el ADN y los aminoácidos durante la síntesis de proteínas.
-
Athur Kornberg aisla la ADN polimerasa; enzima que agrega nucleótidos al extremo 3' de la cadena de ADN. Así mismo, puede corregir daños en el ADN eliminando los nucleótidos equivocados que se agregan accidentalmente a la cadena o que son generados por factores externos.
-
Jerard Hurtwitz y Samuel Weiss descubren la ARN polimerasa. Ésta enzima es fundamental en la transcripción. Utiliza una de las cadenas de ADN molde como plantilla para hacer una nueva molécula de ARN complementaria.
-
John Kendrew y Max Perutz descifran la estructura tridimensional de las proteínas: hemoglobina y mioglobina.
-
-
François Jacob y Jacques Monod formulan concepto de ARNm. Este es el ácido ribonucleico que transfiere el código genético procedente del ADN del núcleo celular a un ribosoma en el citoplasma. Por lo tanto, determina el orden en que se unirán los aminoácidos de una proteína y actúa como plantilla para la síntesis de la misma.
-
François Jacob, Jacques Monod y Andrei Lwoff analizaron el sistema de la lactosa en E. coli. Los resultados de sus estudios permitieron establecer el modelo genético del operón; este permite comprender cómo tiene lugar la regulación de la expresión génica en bacterias.
-
Marshall W. Nirenberg y Henrich Matthaei identificaron los codones, la secuencia de tres unidades químicas del ADN que recogen cada uno de los 20 aminoácidos que forman las moléculas de las proteínas. Es decir, se describe el código genético, así como los procesos en la síntesis de las proteínas.
-
Francis Crick propone la hipótesis del balanceo en la interacción codón-anticodón; que consiste en que un mismo ARNt puede reconocer de manera específica a diferentes codones. Permite menor rigidez en el apareamiento entre la primera posición del anticodón y la tercera.
-
Hamilton Smith descubre las enzimas de restricción, purificando la primera, que fue HindIII, a partir de Haemophilus influenzae. Éstas enzimas reconocen una o un número pequeño de secuencias blanco y corta el ADN en esas secuencias.
-
Paul Berg utilizó las enzimas de restricción y ligasas de ADN para crear la primera molécula recombinante de ADN; para esto se empleó el virus SV40 y el bacteriófago lambda.
-
Tienen lugar los primeros experimentos de ingeniería genética, en los que genes de una especie se introducen en organismos de otra especie y funcionan correctamente.
-
Frederick Sanger empleó la técnica de secuenciación de ADN en el genoma del bacteriófago Phi-X174.
(El genoma del bacteriófago Phi-X174 fue el primer ácido nucleico en ser secuenciado) Este trabajo fue base fundamental para proyectos como el de Genoma Humano. -
Conferencia de Asilomar En ésta se evaluaron los riesgos biológicos de las tecnologías de ADN recombinante y se establecieron diversos principios de bioseguridad con el objetivo de prevenir una fuga accidental de organismos recombinantes que afectaran al ser humano o a los animales. Nació el concepto de principio de precaución en el uso de la naciente ingeniería genética.
-
Edwin Southern publica el método Southern Blot. Procedimiento: Una enzima de restricción se utiliza para cortar una muestra de ADN en fragmentos que se separan mediante electroforesis en gel.
Los fragmentos de ADN son transferidos del gel a la superficie de una membrana. La membrana se expone a una sonda de ADN, si la sonda se une a la membrana, entonces la secuencia de la sonda está presente en la muestra. -
Se funda en Estados Unidos la primera empresa de ingeniería genética. -Robert A. Swanson y Herbert W. Boyer (fundadores)
-
Kary Banks Mullis desarrolló la técnica de la reacción en cadena de la polimerasa, (PCR), una de las técnicas centrales de la biología molecular, que permite la amplificación de una región específica de ADN usando nucleósidos trifosfatados y la acción de una polimerasa de ADN.
-
Primer diagnóstico prenatal de una enfermedad humana por medio del análisis del ADN
-
Se produce el primer ratón transgénico "super-ratón", al insertar el gen de la hormona del crecimiento de la rata en óvulos del ratón hembra fecundados.
-
Alec John Jeffreys desarrolla las huellas genómicas, digiriendo ADN con enzimas de restricción e hibridándolo con sondas radiactivas para caracterizar e identificar individuos.
-
Producción de las primeras plantas transgénicas
-
Yuet Wai Kan y Andree-Marie Dozy descubren los polimorfismos en la longitud de los fragmentos de restricción, que se refiere a secuencias específicas de nucleótidos en el ADN que son reconocidas y cortadas por las enzimas de restricción; éstas varían entre individuos.
-
Se inicia el uso de interferones en el tratamiento de enfermedades víricas. Estos son un grupo de proteínas señalizadoras producidas y secretadas por las células hospederas como respuesta a la presencia de diversos patógenos,
-
Se utiliza por primera vez la "huella genética" en una investigación judicial en Gran Bretaña. Ésta consiste en la identificación de un ser vivo, por las características singulares de su genoma.
-
Constan de una molécula de ADN humano obtenido por ingenieria genetica que son utilizados para clonar secuencias de ADN en células de levadura. Se utilizan para el mapeo y la secuenciación de genomas siendo muy extendido su uso en los primeros años del Proyecto Genoma Humano.
-
Se autorizan las pruebas clínicas de la vacuna contra la hepatitis B obtenida mediante ingeniería genética
-
Comercialización de las primeras máquinas automáticas de secuenciación del ADN.
-
Lanzamiento del programa de investigación colaborativo e internacional cuya meta era la del mapeo (cartografía) y entendimiento completo de todos los genes de los seres humanos.
-
Primer tratamiento con éxito mediante terapia génica en niños con trastornos inmunitarios "niños burbuja". Se ponen en marcha numerosos procedimientos experimentales de terapia génica para intentar curar enfermedades cancerosas y metabólicas.
-
Se comercializa en California el primer vegetal modificado genéticamente: el tomate "Flav Savr" También, se autoriza en Holanda la reproducción del primer toro transgénico.
-
Se completan las primeras secuencias de genomas de seres vivos; en este caso, bacterias. Haemophilus influenzae y Mycoplasma genitalium.
-
Por primera vez se completa la secuencia de un eucarionte, la levadura de la cerveza "Saccharomyces cerevisiae". Así mismo, ha permitido la manipulación genética de los casi 6600 genes que codifica el genoma de ésta. Proporciona un punto de partida para el análisis de organismos eucariotas más complejos.
-
Primer mamífero clonado a partir de una célula adulta. Sus creadores fueron los científicos Ian Wilmut y Keith Campbell. Fue resultado de una combinación nuclear desde una célula donante diferenciada (procedente de la glándula mamaria) a un óvulo no fecundado y anucleado.
-
La UNESCO adopta una declaración universal en 25 artículos sobre el genoma humano y los derechos humanos que prohiben la clonación humana.
-
Desde entonces los investigadores trabajaron sin descanso para convertir el "borrador" de la secuencia en una secuencia "terminada".
-
Se presenta la secuenciación del genoma de Drosophila melanogaster (mosca de la fruta)
-
Significa que la secuencia es altamente exacta con menos de un error por cada 10.000 letras y altamente contiguo, es decir, con los únicos vacíos restantes que corresponden a regiones cuya secuencia no puede ser resuelta de manera segura con la tecnología actual.
-
Se publica la secuencia completa de la primera planta:
Arabidopsis thaliana. -
Presentación del genoma humano por Celera Genomics y el grupo de colaboradores de laboratorios financiados por fundaciones públicas
-
Proyecto de investigación pública lanzado por el Instituto Nacional de Investigación del Genoma Humano de Estados Unidos (NHGRI); busca establecer la enciclopedia de los elementos del ADN humano.
-
Primer transplante de un genoma completo de una bacteria a otra.
Se publica como "transmutación de una especie biológica en otra" en Science. -
Usado para generar un catálogo de los elementos funcionales de la mosca de la fruta (D. melanogaster) y del genoma del gusano C. elegans. Ha sido financiado por el Instituto Nacional de Investigación del Genoma Humano, que forma parte de los Institutos Nacionales de Salud de Estados Unidos.
-
La empresa argentina Bio Sidus obtiene vacunos clonados y transgénicos que portan el gen que codifica para la insulina humana (dinastía Patagonia). Tiene como objetivo obtener la hormona a partir de su leche.
-
Se completa la primera fase del proyecto genoma humano.
-
-
Investigadores del Centro de Regulación Genómica (CRG) de Barcelona (noreste) han descubierto la denominada "ruta Wnt", una serie de reacciones bioquímicas que se producen en las células; éstas desempeñan un papel clave en el proceso de convertir células adultas en células pluripotentes.
-
Biología Molecular: Fundamentos y aplicaciones en las ciencias de la salud. Salazar, Adriana; Sandoval, Ana; Armendáriz, Juan. 2013. Biología Molecular: Fundamentos y aplicaciones. Beas, Carlos; Ortuño, Daniel; Armendáriz, Juan. 2009. https://www.genome.gov/27562859/panorama-general-del-proyecto-del-genoma-humano/
http://www.biology.iupui.edu/biocourses/Biol540/2bkgrnd2k9.html
http://www.bioinformatics.nl/webportal/background/timeline.html
http://www.dnaftb.org/15/bio.html -
http://www.nobelprize.org/nobel_prizes/chemistry/laureates/1954/pauling-bio.html
http://www.thehistoryblog.com/archives/25193
http://genmed.yolasite.com/history.php
http://www.biorom.uma.es/contenido/av_bma/apuntes/T1/t1_nacim.htm
http://www.lifesciencesfoundation.org/eventsPurification_of_DNA.html
http://www.cumc.columbia.edu/psjournal/archive/fall-2003/dna.html
http://www.medtrad.org/panacea/IndiceGeneral/n12_tribuna_GClaros.pdf
Plan projects on a visual timeline
Map milestones, phases, deadlines, and key events in one place so the sequence is easier to see and share. Timetoast is a timeline maker for work, school, research, and stories.